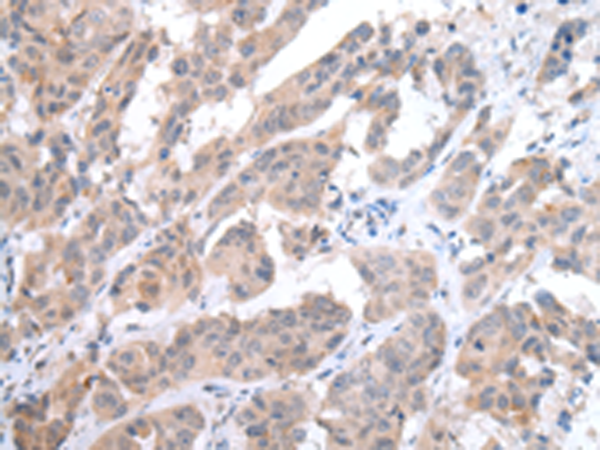

中文名稱: 兔抗CCR6多克隆抗體
儲(chǔ) 存: 冷凍(-20℃)
抗 原: CCR6
宿 主: Rabbit
反應(yīng)種屬: Human
相關(guān)類別: 一抗
標(biāo) 記 物: Unconjugate
克隆類型: rabbit polyclonal
技術(shù)規(guī)格
|
Background: |
This gene encodes a member of the beta chemokine receptor family, which is predicted to be a seven transmembrane protein similar to G protein-coupled receptors. The gene is preferentially expressed by immature dendritic cells and memory T cells. The ligand of this receptor is macrophage inflammatory protein 3 alpha (MIP-3 alpha). This receptor has been shown to be important for B-lineage maturation and antigen-driven B-cell differentiation, and it may regulate the migration and recruitment of dentritic and T cells during inflammatory and immunological responses. Alternatively spliced transcript variants that encode the same protein have been described for this gene. |
|
Applications: |
ELISA, IHC |
|
Name of antibody: |
CCR6 |
|
Immunogen: |
Synthetic peptide of human CCR6 |
|
Full name: |
chemokine (C-C motif) receptor 6 |
|
Synonyms: |
BN-1; DCR2; DRY6; CCR-6; CD196; CKRL3; GPR29; CKR-L3; CMKBR6; GPRCY4; STRL22; CC-CKR-6; C-C CKR-6 |
|
SwissProt: |
P51684 |
|
ELISA Recommended dilution: |
2000-5000 |
|
IHC positive control: |
Human breast cancer and Human thyroid cancer |
|
IHC Recommend dilution: |
20-100 |
購物車
購物車 幫助
幫助
 021-54845833/15800441009
021-54845833/15800441009
